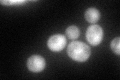
YDR098C
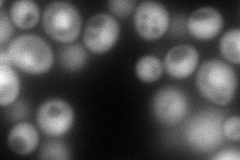
YDR098C
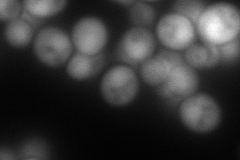
YDR098C
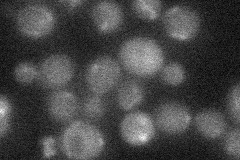
YDR098C
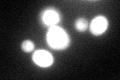
YDR098C
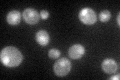
YDR098C

View description
Hydroperoxide and superoxide-radical responsive glutathione-dependent oxidoreductase; monothiol glutaredoxin subfamily member along with Grx4p and Grx5p; protects cells from oxidative damage
Localization:
Intensity:
Fold change:
Significance:
-
C’ GFP library in SD
cytosol:nucleus83.45 -
N' NOP1pr-GFP in SD
cytosol,nucleus148.893 -
N' TEF2pr-mCherry in SD
nucleus184.637 -
N' NATIVEpr-GFP in SD
below threshold22.6548 -
N' TEF2pr-VC and Cyto-VN in SD

#N/A0 -
C’ GFP library in SD+DTT
cytosol.nucleus117.281.4Yes -
C’ GFP library in SD+H2O2

cytosol.nucleus108.411.29No -
C’ GFP library in Starvation Media
cytosol,nucleus85.971.03No -
C’ GFP library on the background of Pup2-DaMP

cytosol:nucleus -
C’ GFP library on the background of CCT mutant

cytosol:nucleus91.01781.09057No
